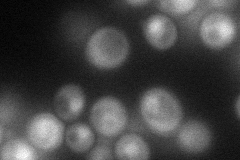
YDL170W
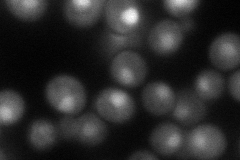
YDL170W
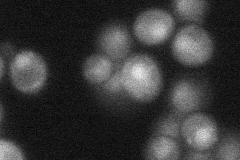
YDL170W
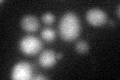
YDL170W

View description
Transcriptional activator necessary for gamma-aminobutyrate (GABA)-dependent induction of GABA genes (such as UGA1, UGA2, UGA4); zinc-finger transcription factor of the Zn(2)-Cys(6) binuclear cluster domain type; localized to the nucleus
Localization:
Intensity:
Fold change:
Significance:
-
C’ GFP library in SD

nucleus17.9 -
N' NOP1pr-GFP in SD
nucleus54.0767 -
N' TEF2pr-mCherry in SD
nucleus68.9825 -
N' NATIVEpr-GFP in SD
nucleus32.0771 -
N' TEF2pr-VC and Cyto-VN in SD

cytosol35.9549 -
C’ GFP library in SD+DTT
nucleus18.881.05No -
C’ GFP library in SD+H2O2

nucleus18.761.04No -
C’ GFP library in Starvation Media

nucleus19.571.09No -
C’ GFP library on the background of Pup2-DaMP

nucleus -
C’ GFP library on the background of CCT mutant

nucleus17.22140.961636No
